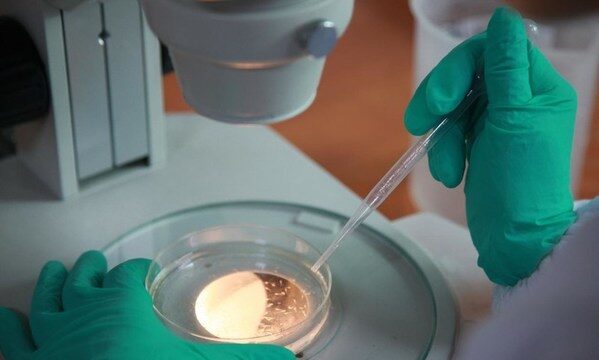

杭州2021年11月3日 /新闻稿网 - Xinwengao.com/ — 11月1日,农业农村部发布了《关于2020-2021年度神农中华农业科技奖的表彰决定》。
由杭州环特生物科技股份有限公司、中国农业科学院农业质量标准与检测技术研究所、浙江省农业科学院联合申报的科研成果 — “农产品中主要危害因子高效识别与风险评估关键技术及应用”荣获2020-2021年度神农中华农业科技奖科学研究类成果一等奖。
这是环特生物继与中国农科院质标所共同成立“农业农村部农产品质量安全生物评价实验室”之后,再次强强联合,并与浙江省农科院三方优势互补,共同斩获的中国农业权威奖项 — 神农中华农业科技奖。
中国农业权威奖项 — 神农中华农业科技奖
“神农中华农业科技奖”是由农业农村部、科技部批准设立的面向全国农业行业唯一综合性农业科技奖,是原农业部科技进步奖的继承和延伸,主要奖励为我国农业科学技术进步和创新方面做出突出贡献的集体和个人,其获奖成果代表农业行业的最高科技发展水平。
此次共授予42项科研成果2020-2021年度神农中华农业科技奖科学研究类成果一等奖,授予47项科研成果神农奖科学研究类成果二等奖,授予60项科研成果神农奖科学研究类成果三等奖,授予26个团队神农奖优秀创新团队奖,授予14项成果神农奖科学普及奖。
农产品中主要危害因子高效识别与风险评估关键技术及应用
此次,环特生物联合中国农业科学院农业质量标准与检测技术研究所、浙江省农业科学院所申报的获奖项目“农产品中主要危害因子高效识别与风险评估关键技术及应用”,作为国家农业、农产品质量安全领域的创新科技成果,针对农产品混合污染物联合毒性效应及机理机制,基于代谢组学研究化学污染物对斑马鱼及其胚胎毒性、确定多种化学物联合毒性效应系数的方法等开展关键技术与应用研究。
通过应用基于UPLC-MS/MS的代谢组学技术,研究rac-/(+)-/(-)-PCB91以及rac-/(-)-/(+)-PCB149对斑马鱼及其胚胎毒性,发现其对22种氨基酸及其他代谢产物具有立体选择毒性影响。同时,基于非相似作用模式下总风险概率模型(ORP)框架,研发可利用体外高通量毒性分析捕获数据,同步实现联合毒性性质(协同、拮抗等)及强度定量估计的方法。
通过高效识别、风险评估和安全预警技术的各项创新研究,本项目不仅以高效、高质量、快速、高通量的斑马鱼生物检测技术,大大弥补了农产品混合污染物安全性评价的短板,完善了现有农产品安全保障控制和风险评估技术体系,为农产品安全生产提供了更完善的技术支撑,并通过构建一站式功效与安全评价解决方案,极大提升了我国农产品的质量安全、营养及精细化、科学化管理水平,对提高我国农产品的国际化竞争力有着深远的意义。
民以食为天,食以安为先。全面促进农业提质增效,坚决守护好居民“舌尖上的安全”,关乎中国农业、农产品的未来。作为中国领先的一站式功效与安全评价研发检测服务平台,未来,环特生物将继续以斑马鱼技术平台为特色中轴、以相关生物实验和理化检测为两翼,持续深化与农产品、营养健康、化妆品、药品等行业科研机构、企业的战略合作深度与广度,以科技赋能产品升级,助力农业、大健康产业高质量发展。